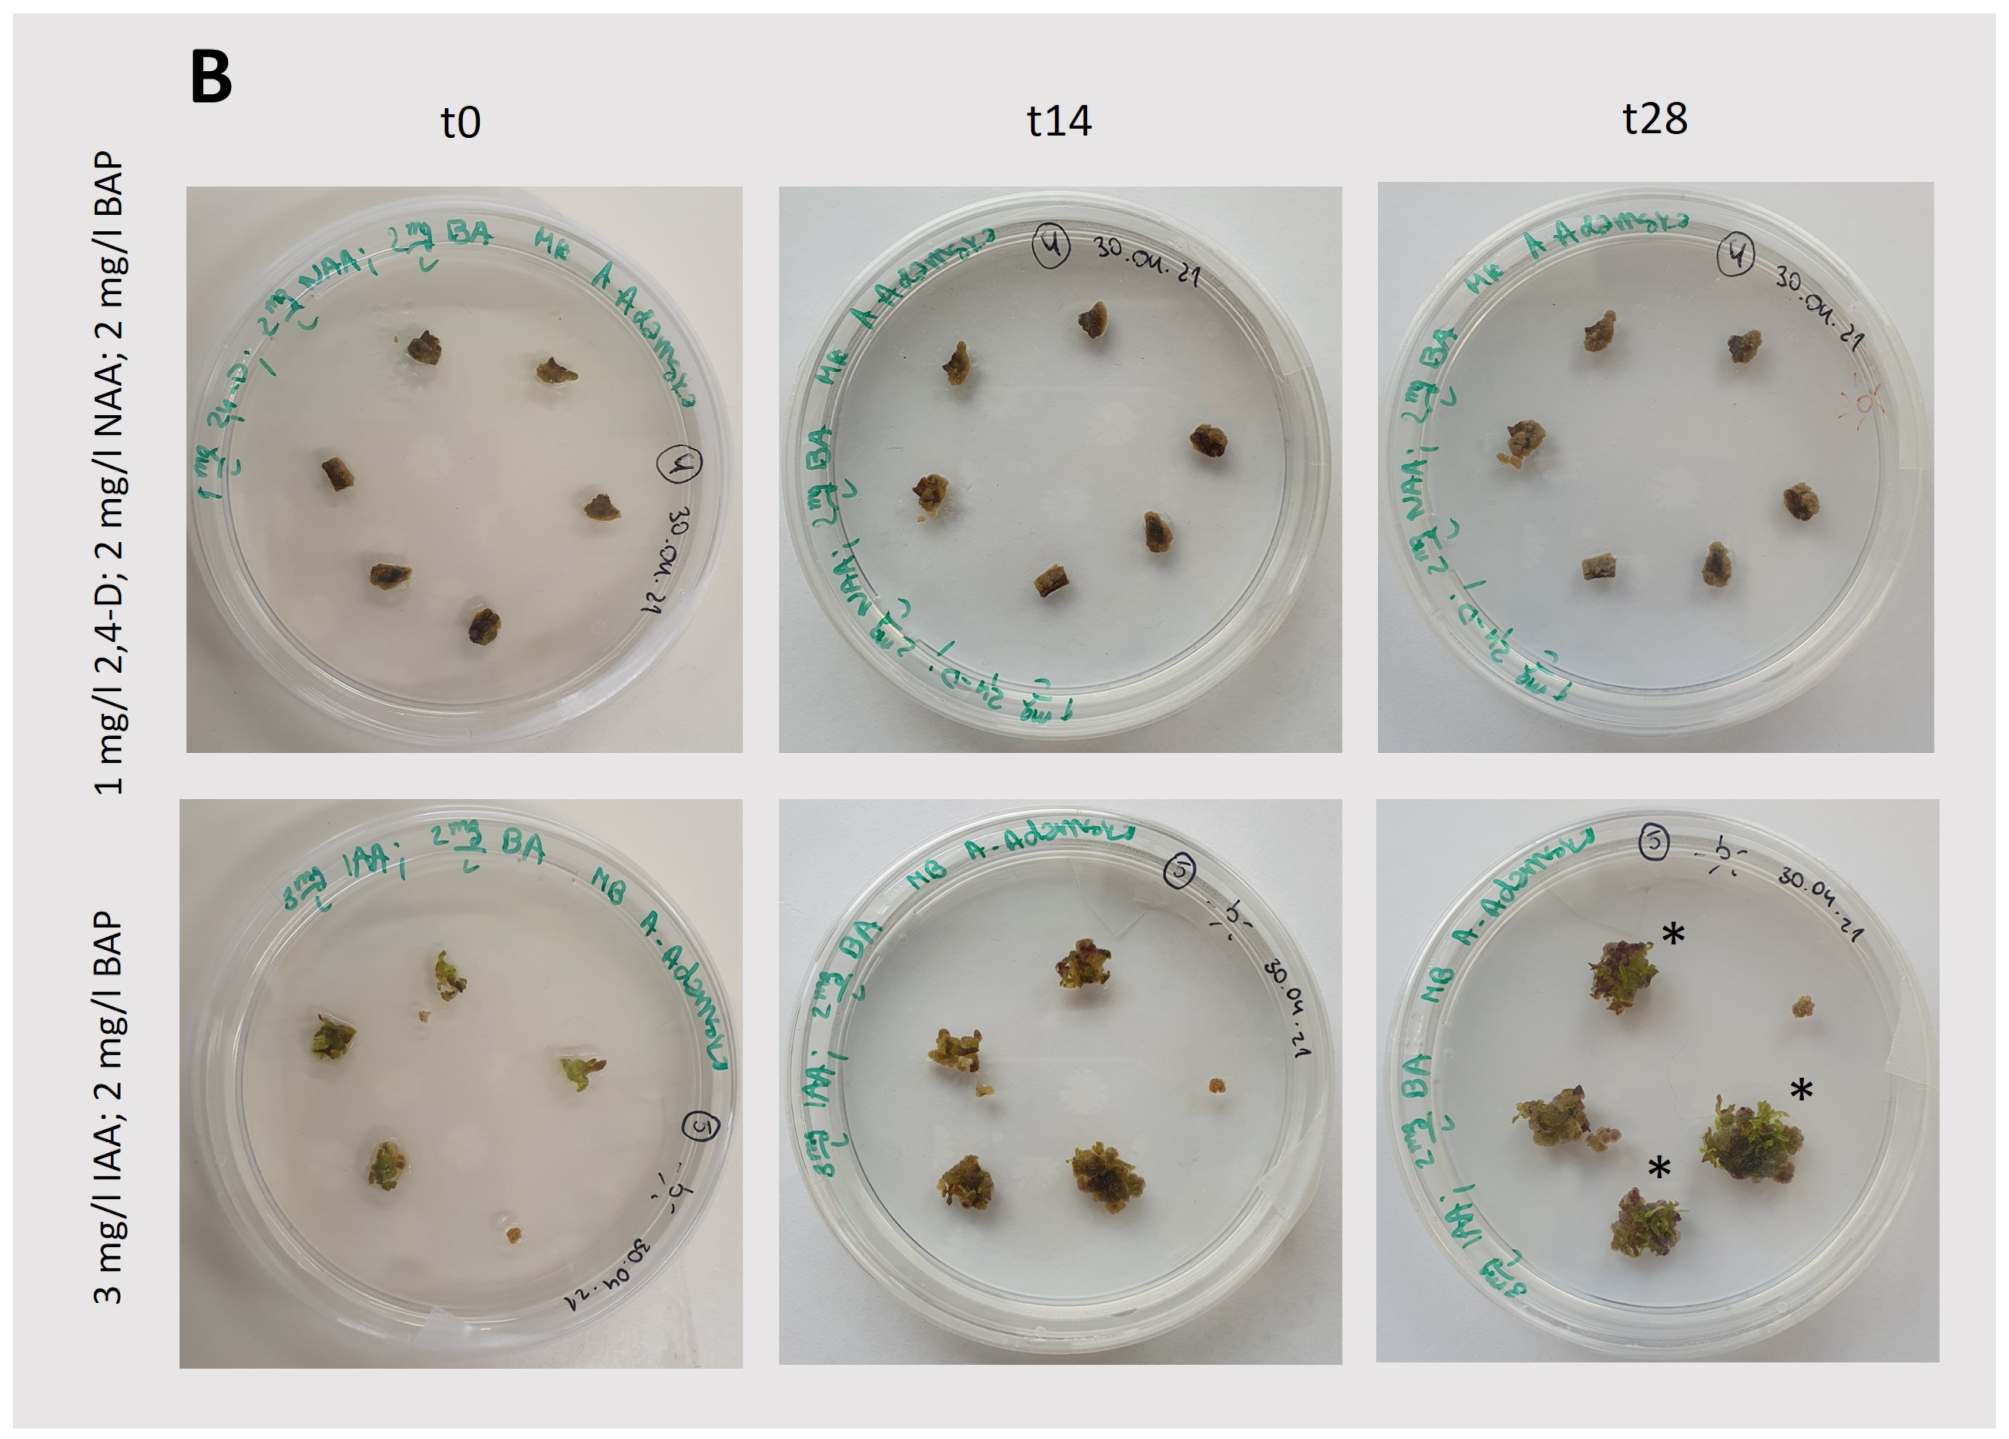
Plants 13 03080 g003b

Induction and Characteristics of Callus Cultures of the Medicinal Plant Tussilago farfara L.
Abstract
1. Introduction
2. Results and Discussion
2.1. Callus Induction
2.2. Analysis of Callus Growth Kinetics
2.3. Organogenesis
2.4. Histological Callus Analysis
2.5. Photosynthetic Activity of Morphogenic Callus
3. Materials and Methods
3.1. Plant Material for Callus Induction
3.2. Callus Induction Protocol
3.3. Callus Growth
3.4. Callus Growth Kinetics
3.5. Biochemical Analysis
3.6. Observation of Callus Tissue
3.7. Histological Analysis of Callus Formation
3.8. Chlorophyll In Vivo Fluorescence Measurements
4. Conclusions
Author Contributions
Funding
Data Availability Statement
Conflicts of Interest
References
- Available online: https://powo.science.kew.org/taxon/urn:lsid:ipni.org:names:256904-1 (accessed on 19 September 2024).
- Tobyn, G.; Denham, A.; Whitelegg, M. (Eds.) CHAPTER 30—Tussilago farfara, coltsfoot. In Medical Herbs; Churchill Livingstone: Edinburgh, UK, 2011; pp. 317–326. [Google Scholar] [CrossRef]
- Matuszkiewicz, W. Przewodnik do Oznaczania Zbiorowisk Roślinnych Polski; Wydawnictwo Naukowe PWN: Warszawie, Poland, 2006. [Google Scholar]
- Chen, S.; Dong, L.; Quan, H.; Zhou, X.; Ma, J.; Xia, W.; Zhou, H.; Fu, X. A review of the ethnobotanical value, phytochemistry, pharmacology, toxicity and quality control of Tussilago farfara L. (coltsfoot). J. Ethnopharmacol. 2021, 267, 113478. [Google Scholar] [CrossRef]
- Adamczak, A.; Opala, B.; Gryszczyńska, A.; Buchwald, W. Content of pyrrolizidine alkaloids in the leaves of coltsfoot (Tussilago farfara L.) in Poland. Acta Soc. Bot. Pol. 2013, 82, 289–293. [Google Scholar] [CrossRef]
- Bota, V.B.; Neamtu, A.A.; Olah, N.K.; Chișe, E.; Burtescu, R.F.; Furtuna, F.R.P.; Nicula, A.S.; Neamtu, C.; Maghiar, A.M.; Ivănescu, L.C.; et al. A Comparative Analysis of the Anatomy, Phenolic Profile, and Antioxidant Capacity of Tussilago farfara L. Vegetative Organs. Plants 2022, 11, 1663. [Google Scholar] [CrossRef] [PubMed]
- Efferth, T. Biotechnology Applications of Plant Callus Cultures. Engineering 2019, 5, 50–59. [Google Scholar] [CrossRef]
- Acharjee, S.; Kumar, R.; Kumar, N. Role of plant biotechnology in enhancement of alkaloid production from cell culture system of Catharanthus roseus: A medicinal plant with potent anti-tumor properties. Ind. Crop. Prod. 2022, 176, 114298. [Google Scholar] [CrossRef]
- Ikeuchi, M.; Sugimoto, K.; Iwase, A. Plant callus: Mechanisms of induction and repression. Plant Cell 2013, 25, 3159–3173. [Google Scholar] [CrossRef]
- Yin, R.; Chen, R.; Xia, K.; Xu, X. A single-cell transcriptome atlas reveals the trajectory of early cell fate transition during callus induction in Arabidopsis. Plant Commun. 2024, 5, 100941. [Google Scholar] [CrossRef]
- Thakur, K.; Partap, M.; Kumar, P.; Sharma, R.; Warghat, A.R. Understandings of bioactive composition, molecular regulation, and biotechnological interventions in the development and usage of specialized metabolites as health-promoting substances in Siraitia grosvenorii (Swingle) C. Jeffrey. J. Food Compos. Anal. 2023, 116, 105070. [Google Scholar] [CrossRef]
- Palanivel, S.; Parvathi, S.; Jayabalan, N. Callus induction and plantlet regeneration from mature cotyledonary segments of groundnut (Arachis hypogaea L.). J. Plant Biol. 2002, 45, 22–27. [Google Scholar] [CrossRef]
- Ren, J.W.; Lei, Y.; Li, X.L. Tissue culture of callus and establishment of regeneration system of Tussilago farfara petiole. Zhongguo Zhong Yao Za Zhi 2017, 42, 3895–3900. [Google Scholar] [CrossRef]
- Shah, M.; George, I.A. Pigment elicitation and sun protection factor of callus induced from Cassia tora seedling explants. Plant Cell Tissue Organ Cult. 2020, 143, 201–210. [Google Scholar] [CrossRef]
- Wang, K.T.; Hong, M.C.; Wu, Y.S.; Wu, T.M. Agrobacterium-mediated genetic transformation of taiwanese isolates of lemna aequinoctialis. Plants 2021, 10, 1576. [Google Scholar] [CrossRef] [PubMed]
- Hunt, R. Growth Analysis, Individual Plants. In Encyclopedia of Applied Plant Sciences, 2nd ed.; Thomas, B., Murray, B.G., Murphy, D.J., Eds.; Academic Press: Oxford, UK, 2017; pp. 421–429. [Google Scholar] [CrossRef]
- Gantait, S.; Das, A.; Mitra, M.; Chen, J.T. Secondary metabolites in orchids: Biosynthesis, medicinal uses, and biotechnology. S. Afr. J. Bot. 2021, 139, 338–351. [Google Scholar] [CrossRef]
- Genty, B.; Briantais, J.; Baker, N. The relationship between the quantum yield of photosynthetic electron transport and quenching of chlorophyll fluorescence. Biochim. Biophys. Acta 1989, 990, 87–92. Available online: https://www.sciencedirect.com/science/article/pii/S0304416589800169 (accessed on 23 October 2022). [CrossRef]
- Silva, A.L.C.D.; Caruso, C.S.; Moreira, R.D.A.; Horta, A.C.G. Growth characteristics and dynamics of protein synthesis in callus cultures from Glycine wightii (Wight & Arn.) Verdc. Ciência Agrotecnologia 2005, 29, 1161–1166. [Google Scholar] [CrossRef]
- Pajević, S.; Vasić, D.; Sekulić, P. Biochemical Characteristics and Nutrient Content of the Callus of Sunflower Inbred Lines. Helia 2004, 27, 143–150. [Google Scholar] [CrossRef]
- Kumar, N.; Pamidimarri, S.D.V.N.; Kaur, M.; Boricha, G.; Reddy, M.P. Effects of NaCl on growth, ion accumulation, protein, proline contents and antioxidant enzymes activity in callus cultures of Jatropha curcas. Biologia 2008, 63, 378–382. [Google Scholar] [CrossRef]
- Simões, C.; Bizarri, C.H.B.; da Silva Cordeiro, L.; de Castro, T.C.; Coutada, L.C.M.; da Silva, A.J.R.; Albarello, N.; Mansur, E. Anthocyanin production in callus cultures of Cleome rosea: Modulation by culture conditions and characterization of pigments by means of HPLC-DAD/ESIMS. Plant Physiol. Biochem. 2009, 47, 895–903. [Google Scholar] [CrossRef]
- Pashkovskiy, P.P.; Soshinkova, T.N.; Korolkova, D.V.; Kartashov, A.V.; Zlobin, I.E.; Lyubimov, V.Y.; Kreslavski, V.D.; Kuznetsov, V.V. The effect of light quality on the pro-/antioxidant balance, activity of photosystem II, and expression of light-dependent genes in Eutrema salsugineum callus cells. Photosynth. Res. 2018, 136, 199–214. [Google Scholar] [CrossRef]
- Dale, M.P.; Causton, D.R. Use of the Chlorophyll a/b Ratio as a Bioassay for the Light Environment of a Plant. Funct. Ecol. 1992, 6, 190–196. [Google Scholar] [CrossRef]
- Cazzonelli, C.I.; Pogson, B.J. Source to sink: Regulation of carotenoid biosynthesis in plants. Trends Plant Sci. 2010, 15, 266–274. [Google Scholar] [CrossRef]
- Siegień, I.; Adamczuk, A.; Wróblewska, K. Light affects in vitro organogenesis of Linum usitatissimum L. and its cyanogenic potential. Acta Physiol. Plant. 2013, 35, 781–789. [Google Scholar] [CrossRef] [PubMed]
- Miguel, J.F. Effect of Light Conditions on In Vitro Adventitious Organogenesis of Cucumber Cultivars. Int. J. Plant Anim. Environ. Sci. 2022, 12, 138–144. [Google Scholar] [CrossRef]
- Esteves, P.; Clermont, I.; Marchand, S.; Belzile, F. Improving the efficiency of isolated microspore culture in six-row spring barley: II-exploring novel growth regulators to maximize embryogenesis and reduce albinism. Plant Cell Rep. 2014, 33, 871–879. [Google Scholar] [CrossRef] [PubMed]
- Symons, G.M.; Reid, J.B. Interactions between Light and Plant Hormones during De-etiolation. J. Plant Growth Regul. 2003, 22, 3–14. [Google Scholar] [CrossRef]
- Gałuszka, A.; Gustab, M.; Tuleja, M. In vitro morphogenetic responses from obligatory apomictic Taraxacum belorussicum Val. N. Tikhom seedlings explants. Plant Cell Tissue Organ Cult. 2019, 139, 505–522. [Google Scholar] [CrossRef]
- Popielarska-Konieczna, M.; Kozieradzka-Kiszkurno, M.; Świerczyńska, J.; Góralski, G.; Ślesak, H.; Bohdanowicz, J. Are extracellular matrix surface network components involved in signalling and protective function? Plant Signal. Behav. 2008, 3, 707–709. [Google Scholar] [CrossRef]
- Šamaj, J.; Bobák, M.; Blehová, A.; Pret’Ová, A. Importance of cytoskeleton and cell wall in somatic embryogenesis. Plant Cell Monogr. 2005, 2, 35–50. [Google Scholar] [CrossRef]
- Šamaj, J.; Baluška, F.; Bobák, M.; Volkmann, D. Extracellular matrix surface network of embryogenic units of friable maize callus contains arabinogalactan-proteins recognized by monoclonal antibody JIM4. Plant Cell Rep. 1999, 18, 369–374. [Google Scholar] [CrossRef]
- Popielarska-Konieczna, M.; Sala, K.; Abdullah, M.; Tuleja, M.; Kurczyńska, E. Extracellular matrix and wall composition are diverse in the organogenic and non-organogenic calli of Actinidia arguta. Plant Cell Rep. 2020, 39, 779–798. [Google Scholar] [CrossRef]
- Zabicki, P.; Kuta, E.; Tuleja, M.; Rataj, K.; Malec, P. Arabidopsis cyclin-dependent kinase gene CDKG;2 is involved in organogenic responses induced in vitro. Acta Biol. Crac. Ser. Bot. 2013, 55, 37–48. [Google Scholar] [CrossRef]
- Wetmore, R.H.; Rier, J.P. Experimental Induction of Vascular Tissues in Callus of Angiosperms. Am. J. Bot. 1963, 50, 418–430. [Google Scholar] [CrossRef]
- Jeffs, R.A.; Northcote, D.H. Experimental induction of vascular tissue in an undifferentiated plant callus. Biochem. J. 1966, 101, 146. [Google Scholar] [CrossRef] [PubMed]
- Ullrich, C.I.; Aloni, R. Vascularization is a general requirement for growth of plant and animal tumours. J. Exp. Bot. 2000, 51, 1951–1960. [Google Scholar] [CrossRef]
- Häsler, J.; Wüest, J.; Gaspar, T.; Crèvecoeur, M. Long term in vitro-cultured plant cells show typical neoplastic features at the cytological level. Biol. Cell 2003, 95, 357–364. [Google Scholar] [CrossRef]
- Ušák, D.; Haluška, S.; Pleskot, R. Callose synthesis at the center point of plant development—An evolutionary insight. Plant Physiol. 2023, 193, 54–69. [Google Scholar] [CrossRef]
- Björkman, O.; Demmig, B. Photon yield of O2 evolution and chlorophyll fluorescence characteristics at 77 K among vascular plants of diverse origins. Planta 1987, 170, 489–504. [Google Scholar] [CrossRef]
- Lang, J.; Pankowski, J.; Grabarz, P.; Pluciński, B.; Jedynak, P. Comparing the effects of different exogenous hormone combinations on seed-derived callus induction in Nicotiana tabacum. Acta Biochim. Pol. 2020, 67, 449–452. [Google Scholar] [CrossRef]
- Solymosi, K.; Mysliwa-Kurdziel, B. The Role of Membranes and Lipid-Protein Interactions in the Mg-Branch of Tetrapyrrole Biosynthesis. Front. Plant Sci. 2021, 12, 663309. [Google Scholar] [CrossRef]
- Armarego-Marriott, T.; Sandoval-Ibañez, O.; Kowalewska, Ł. Beyond the darkness: Recent lessons from etiolation and de-etiolation studies. J. Exp. Bot. 2020, 71, 1215–1225. [Google Scholar] [CrossRef]
- Franck, F.; Schoefs, B.; Barthelemy, X.; Mysliwa-Kurdziel, B.; Strzalka, K.; Popovic, R. Protection of native chlorophyll(ide) forms and of photosystem II against photodamage during early stages of chloroplast differentiation. Acta Physiol. Plant 1995, 17, 123–132. [Google Scholar]
- Garmash, E.V.; Dymova, O.V.; Malyshev, R.V.; Plyusnina, S.N.; Golovko, T.K. Developmental changes in energy dissipation in etiolated wheat seedlings during the greening process. Photosynthetica 2013, 51, 497–508. [Google Scholar] [CrossRef]
- Horton, P.; Ruban, A.V.; Walters, R.G. Regulation of light harvesting in green plants. Annu. Rev. Plant Physiol. Plant Mol. Biol. 1996, 47, 655–684. [Google Scholar] [CrossRef] [PubMed]
- Horton, P.; Ruban, A.V. Regulation of Photosystem II. Photosynth. Res. 1992, 34, 375–385. [Google Scholar] [CrossRef]
- Lichtenthaler, H.K.; Buschmann, C.; Knapp, M. How to correctly determine the different chlorophyll fluorescence parameters and the chlorophyll fluorescence decrease ratio RFd of leaves with the PAM fluorometer. Photosynthetica 2005, 43, 379–393. [Google Scholar] [CrossRef]
- Murashige, T.; Skoog, F. A revised medium for rapid growth and bioassays with tobacco tissue culture. Physiol. Plant 1962, 15, 473–497. [Google Scholar] [CrossRef]
- Kȩdra, M.; Bach, A. Morphogenesis of Lilium martagon L. explants in callus culture. Acta Biol. Crac. Ser. Bot. 2005, 47, 65–73. [Google Scholar]
- Lowry, O.H.; Rosebrough, N.J.; Farr, A.L.; Randall, R.J. Protein measurement with the Folin phenol reagent. J. Biol. Chem. 1951, 193, 265–275. [Google Scholar] [CrossRef]
- Lichtenthaler, H.; Buschmann, C. Chlorophyll and Carotenoid Determination (after Lichtenthaler 1987), a practical instruction. Methods Enzym. 1987, 8, 350–382. [Google Scholar]
- Giusti, M.M.; Wrolstad, R.E. Characterization and Measurement of Anthocyanins by UV-Visible Spectroscopy. In Current Protocols in Food Analytical Chemistry; John and Wiley and Sons: Hoboken, NJ, USA, 2001. [Google Scholar] [CrossRef]
- Jensen, W.A. Botanical Histochemistry Principles and Practice; W. H. Freeman and Company: San Francisco, CA, USA; London, UK, 1962. [Google Scholar]
- Tuleja, M.; Santocki, M.; Dziurka, M.; Musiał, K.; Capecka, E.; Libik-Konieczny, M. The search towards cyto-embryological and physiological obstacles in sexual reproduction of Stevia rebaudiana Bertoni. Sci. Hortic. 2021, 288, 110342. [Google Scholar] [CrossRef]
- Kalaji, H.M.; Schansker, G.; Ladle, R.J.; Goltsev, V.; Bosa, K.; Allakhverdiev, S.I.; Brestic, M.; Bussotti, F.; Calatayud, A.; Dąbrowski, P.; et al. Frequently asked questions about in vivo chlorophyll fluorescence: Practical issues. Photosynth. Res. 2014, 122, 121–158. [Google Scholar] [CrossRef]
- Kalaji, H.M.; Schansker, G.; Brestic, M.; Bussotti, F.; Calatayud, A.; Ferroni, L.; Goltsev, V.; Guidi, L.; Jajoo, A.; Li, P.; et al. Frequently asked questions about chlorophyll fluorescence, the sequel. Photosynth. Res. 2016, 132, 13–66. [Google Scholar] [CrossRef]

| Growth Conditions | Hormone Composition in MS Medium | Callus Initiation [+++/−] | ||
|---|---|---|---|---|
| Light | 2,4-D (1 mg/L) | NAA (2 mg/L) | BAP (2 mg/L) | + |
| 2,4-D (1.5 mg/L) | NAA (2 mg/L) | BAP (2 mg/L) | + | |
| 2,4-D (2 mg/L) | NAA (2 mg/L) | BAP (2 mg/L) | + | |
| IAA (3 mg/L) | - | BAP (2 mg/L) | ++ | |
| Dark | 2,4-D (1 mg/L) | NAA (2 mg/L) | BAP (2 mg/L) | + |
| 2,4-D (2 mg/L) | - | BAP (3 mg/L) | +/− | |
| IAA (3 mg/L) | - | BAP (2 mg/L) | +++ | |
| IAA (2 mg/L) | - | BAP (2 mg/L) | ++ | |
| Plant Material | Chl a [ng/mg] | Chl b [ng/mg] | Carotenoids [ng/mg] | Chl a/ Chl b | Chl/ Carotenoids |
|---|---|---|---|---|---|
| Light conditions | |||||
| leaves | 1095.3 ± 148.6 | 345.5 ± 45.0 | 244.3 ± 32.1 | 3.17 ± 0.04 | 5.90 ± 0.22 |
| callus | 33.5 ± 9.6 | 16.3 ± 1.96 | 17.06 ± 4.13 | 2.03 ± 0.40 | 2.93 ± 0.05 |
| Dark conditions (*) | |||||
| callus | 0.78 ± 0.56 | 1.48 ± 0.88 | 3.51 ± 0.58 | 0.50 ± 0.08 | 0.66 ± 0.40 |
| Growth Conditions | Medium | Callus Color and Tint with Another Color [%] | Calli with Organogenesis | White Organs [Number] | Green Organs [Number] | |||||
|---|---|---|---|---|---|---|---|---|---|---|
| [%] | [Number] | R | L | S | R | L | S | |||
| Light | MS | light brown tinted on dark brown (10.9) on violet (13) | 21.8 | 10 | 2 | 9 | 2 | 0 | 17 | 3 |
| MS + IAA (3 mg/L), BAP (2 mg/L) | light brown tinted on dark brown (26.1), on yellow (26.1) on violet (45) | 23.9 | 11 | 14 | 14 | 8 | 0 | 1 | 0 | |
| Dark | MS | brown tinted on yellow (13) | 19.4 | 9 | 11 | 4 | 3 | 0 | 0 | 0 |
| MS + IAA (3 mg/L), BAP (2 mg/L) | light yellow tinted on brown (15.2) on violet (17.4) | 17.4 | 8 | 17 | 2 | 0 | 0 | 0 | 0 | |
Disclaimer/Publisher’s Note: The statements, opinions and data contained in all publications are solely those of the individual author(s) and contributor(s) and not of MDPI and/or the editor(s). MDPI and/or the editor(s) disclaim responsibility for any injury to people or property resulting from any ideas, methods, instructions or products referred to in the content. |
© 2024 by the authors. Licensee MDPI, Basel, Switzerland. This article is an open access article distributed under the terms and conditions of the Creative Commons Attribution (CC BY) license (https://creativecommons.org/licenses/by/4.0/).
Share and Cite
Bojko, M.; Kędra, M.; Adamska, A.; Jakubowska, Z.; Tuleja, M.; Myśliwa-Kurdziel, B. Induction and Characteristics of Callus Cultures of the Medicinal Plant Tussilago farfara L. Plants 2024, 13, 3080. https://doi.org/10.3390/plants13213080
Bojko M, Kędra M, Adamska A, Jakubowska Z, Tuleja M, Myśliwa-Kurdziel B. Induction and Characteristics of Callus Cultures of the Medicinal Plant Tussilago farfara L. Plants. 2024; 13(21):3080. https://doi.org/10.3390/plants13213080
Chicago/Turabian StyleBojko, Monika, Magdalena Kędra, Agata Adamska, Zuzanna Jakubowska, Monika Tuleja, and Beata Myśliwa-Kurdziel. 2024. "Induction and Characteristics of Callus Cultures of the Medicinal Plant Tussilago farfara L." Plants 13, no. 21: 3080. https://doi.org/10.3390/plants13213080
APA StyleBojko, M., Kędra, M., Adamska, A., Jakubowska, Z., Tuleja, M., & Myśliwa-Kurdziel, B. (2024). Induction and Characteristics of Callus Cultures of the Medicinal Plant Tussilago farfara L. Plants, 13(21), 3080. https://doi.org/10.3390/plants13213080

